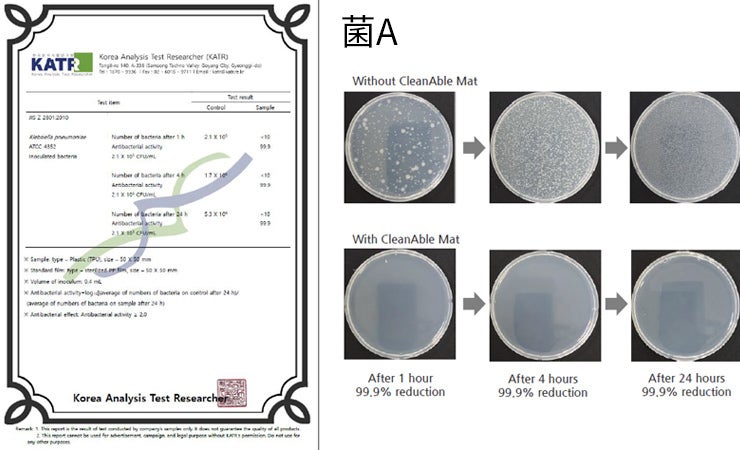

自粛ムード漂う中のテレワーク、オフィスワーク、
1日のうちで、1番長い時間を過ごすデスク周り。


作業の合間のティータイム、お茶を飲んだり、お菓子も食べたり。
そんな中、知らず知らずデスクの様々なところを触ってしまいがち。

そんな、デスクを触った手でうっかり顔を触ると、
誰が触ったか分からないデスクに付着している細菌などが体内に・・。

でも、もう心配は要りません。
あなたにはこれがあるから。

この抗菌デスクマットを敷いてしまえば、たちまちそこが安全ゾーンに変わります。
長い時間を過ごすデスク上ですから、清潔で安心な環境で作業したいですよね。

このマットの表面は、強力な抗菌仕上げ。
ジオライト、銅、および無機抗菌剤である亜鉛が含まれています。これらは人体に無害であり、さまざまな細菌の成長を阻害し、99.9%の抗菌力を半永久的に維持します。
そして裏面は、滑り止め加工。
・検査実施機関:Korea Analysis Test Researcher / http://katr.re.kr/
・検査地:A 1102, Digital Empire Building, 16, Deogyeong daero 1556beon gil, Yeongtonggu, Suwonsi, Gyeonggi do, South Korea
・検査実施時期:2020/9/10~28
・検査内容結果:JIS Z 2801:2010抗菌加工製品-抗菌性試験方法・抗菌効果→抗菌効果あり
菌Aのテスト結果をご覧ください。
通常菌が付着してから4時間後、24時間後と増殖を繰り返し無数の菌だらけになるところ、この抗菌マットの上に付着した菌Aは、1時間後に99.9%死滅、24時間後もそれをキープ。
※複数の菌種でテストレポートがありますが、全ての菌の成長を阻害する訳ではありません。

・検査実施機関:Intertek Testing Services Korea Ltd. / http://www.intertek.co.kr/
・検査地:7, Achasan-ro 5-gil, Seongdong-gu, Seoul, 04793 Korea
・検査実施時期:2020/11/17~23
・検査内容結果:カドミウム、鉛、水銀など有害物質に対しての含有確認試験(IEC62321-5 Edition1.0 他)→非含有。
強力な抗菌作用のあるマットですが、人体に有害であれば意味を成しません。
重金属の残留テストを行い、人体に無害であることを証明しています。

液体をこぼしても、抗菌作用に変わりはありません。
サッとペーパータオルなどで拭き上げるだけ。もちろん水洗いも可能です。




製品名:Qurra 抗菌デスクマット
カラー:ライトグレー、ダークグレー
素材:TPU
サイズ:500 x 320 x 1.2 (mm)
※長期保管中は、直射日光をお避け下さい。
※製品の表面が汚れている場合は、きれいに拭いてください。(ウェットティッシュ、水洗いでOK)
※乳幼児の口に入れないようご注意ください。
※火のそばに置いたり、加熱したりしないでください。
※完全に折りたたむと、折り目が残る場合がございます。
※先のとがった物や鋭利な物で表面を傷つけると、抗菌力が低下します。
※照明やモニタなどにより、商品の色合いが若干異なって見える場合がございます。
この価格は、CAMPFIREだけに特別に用意したものです。一般販売よりも先に、いち早くこの「Qurra 抗菌デスクマット」を手に入れることができます。今すぐ、一番お得な価格で手に入れて下さい。
2021年3月1日(月) プロジェクト終了
2021年3月上旬 支援者様へ発送
スリーアールソリューション株式会社はPC・スマホ週辺機器、顕微鏡や内視鏡などの検査機器、美容機器、ゲーミング機器、ノベルティグッズなど、お客様のニーズを満たす製品の開発・製造・販売を行っている福岡発のメーカーです。
私たちスリーアールソリューションは社名の通り、お客様の「問題解決」が使命です。日々の暮らしや仕事の中で起こる、お悩みやお困りごとを解決する画期的な商品をお届けできるよう、商品開発に取り組んでまいります。
スリーアールソリューション株式会社
設立 2016年4月
代表取締役社長 今村 陽一
取締役 中川 伸吾
本社
〒812-0008
福岡市博多区東光2丁目8-30高光第一ビル2階
東京支店
〒110-0015
東京都台東区東上野2丁目8番1号 ウインドミルビル2階
リスク&チャレンジ
・商品の生産には万全を期していますが、予期せぬ事態によりお届けが遅れる場合がございます。 その際は活動レポートにて速やかにご報告致します。
・本プロジェクトを通して想定を上回る皆様からご支援を頂き、現在進めている環境から量産体制を更に整えることができた場合、正規販売価格が販売予定価格より下がる可能性もございます。
・弊社製品に類似の製品が市場で流通している可能性もあるため、ご了承の上、購入ください。
・ご⽀援後のご⽀援者様都合によるキャンセルや返⾦はお受け出来ませんのでご了解下さい。
・本製品は初期不良のみ保証します。(お客様の故意・過失等で生じた故障は除きます)
特定商取引法に関する記載
◯ 販売事業者名: スリーアールソリューション株式会社
◯ 事業者の所在地:〒812-0008 福岡県福岡市博多区東光2丁目8−30 高光第一ビル2階
◯ 事業者の連絡先:Tel: 092-260-3030 メール: account3r2@3rrr-hd.jp
※こちらでは当該製品に対するお申し込み、質問等は受け付けておりません。
◯ 商品の販売価格・役務の対価:各リターン記載のとおり
◯ 対価以外に必要な費用:プロジェクトページ、リターンに記載のとおり
◯ 申込期限:当ページ記載のプロジェクト終了期限どおり
◯ 代金の支払時期:各プロジェクトが募集期間内に成立した時点で、支援金の決済が行われます。All-in方式の場合は即時で決済されます。コンビニ払いは、コンビニエンスストアで所定の方法により支払いが完了した時点で、決済が行われます。銀行振込(ペイジー払い)は、ATMまたはネットバンキングにて所定の方法により支払いが完了した時点で、決済が行われます。auかんたん決済、ソフトバンクまとめて支払い・ワイモバイルまとめて支払い、ドコモ払い、Paypayは各決済画面により支払いが完了した時点で決済が行われます。
◯ 支払方法:クレジットカード払い(Visa/Mastercard/JCB/Diners Club/American Express)/コンビニ払い(全国の主要コンビニエンスストア)/銀行振込(銀行ATM・ネットバンキング)/auかんたん決済/ソフトバンクまとめて支払い・ワイモバイルまとめて支払い/ドコモ払い/PayPal/Paypay。お支払いの手数料に関して、コンビニ払いの場合 350円(税込)が、お客様のご負担となります。また、銀行振込ご利用の場合は、所定の振込手数料がお客様のご負担となります。
◯ 商品引渡しまたは役務提供の時期:各プロジェクトが募集期間内に成立した場合のみ、支援金の決済が行われ、約定されたリターンを得る権利が発生します。なお、リターン毎の発送(履行)時期は各プロジェクトの記載・連絡に準じます。諸般の事情により遅延・遅配が生じる場合は、プロジェクトオーナーより記載・連絡されるものとします。
◯ キャンセル・返品: 利用規約記載のとおり、お客様都合による返品・キャンセルはできませんのでご注意ください。尚、製品到着後に破損や初期不良がある場合には交換させていただきますので「メッセージで意見や問い合わせを送る」から、または納品書記載の連絡先までお問い合わせください。
※上記以外の事項に関しては、お取引の際に請求があれば遅延なく提示いたします。
最新の活動報告
もっと見る
【デスクに敷くだけで99.9%の抗菌力】お子様の勉強机の感染対策にも!
2021/02/21 12:00この度は「Qurra 抗菌デスクマット」のプロジェクトページをご覧いただき、誠にありがとうございます。この商品は、大人のデスクワークだけではなく、お子様の勉強机の感染対策にも大変有効です。お子様は、大人と比べてこまめな除菌が疎かになりがち。学校から持ち帰った教科書やノート、筆記用具などを勉強机に並べて、その一つ一つを除菌するのは至難の業です。そんな時、「Qurra 抗菌デスクマット」を勉強机に1枚敷いてあげましょう。99.9%の抗菌力で、お子様を細菌から守ってくれます。こまめな除菌が難しいお子様に、安心して勉強に向き合っていただけるよう、ぜひ「Qurra 抗菌デスクマット」のご支援・ご検討をよろしくお願いいたします。 もっと見る
「Qurra 抗菌デスクマット」机の上でのお食事にも安心です
2021/02/20 12:00この度は「Qurra 抗菌デスクマット」のプロジェクトページをご覧いただき、誠にありがとうございます。この商品は、デスクワーク中はもちろん、お食事の際の感染対策としても大変効果的です。お食事の際、皆様テーブルをしっかりと拭かれているかと思いますが、綺麗に拭きあげても、どうしても微細な菌や汚れが残ってしまいがちです。そんな時、こちらの抗菌デスクマットをランチョンマット代わりに敷くだけで、机の上の細菌からお食事を守ることができます。お食事の際は、特に感染リスクから身を守りたいですよね。この機会に、ぜひ「Qurra 抗菌デスクマット」 のご支援・ご検討をよろしくお願いいたします。 もっと見る
【デスクに敷くだけで99.9%の抗菌力】テレワークのデスク感染対策はお済ですか?
2021/02/19 13:00この度は「Qurra 抗菌デスクマット」のプロジェクトページをご覧いただき、誠にありがとうございます。デスクワーク中、スマホを触ったり、お菓子をつまんだり、書類やペンを触ったり、気づかぬうちに色々なものに触れています。毎回除菌をするのは面倒。そんな時は、この「Qurra 抗菌デスクマット」をデスクに敷くだけでOK。99.9%の抗菌力を発揮してくれます。マウスパッドとしても使用可能です。1枚敷くだけで安心してお仕事に集中できる。そんな便利な「Qurra 抗菌デスクマット」 、ぜひご支援・ご検討をよろしくお願いいたします。 もっと見る






コメント
もっと見る